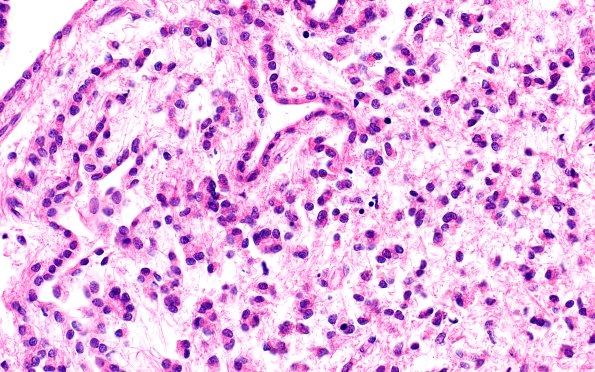
10A4 Ependyma, lateral ventricle (Case 10) N2 40X

Table of Contents
Washington University Experience | NORMAL | Ependyma | 10A4 Ependyma, lateral ventricle (Case 10) N2 40X
Increasing magnification images of the lateral ventricle wall overlying the caudate nucleus containing large numbers of dissociated ependymal cells. (H&E)